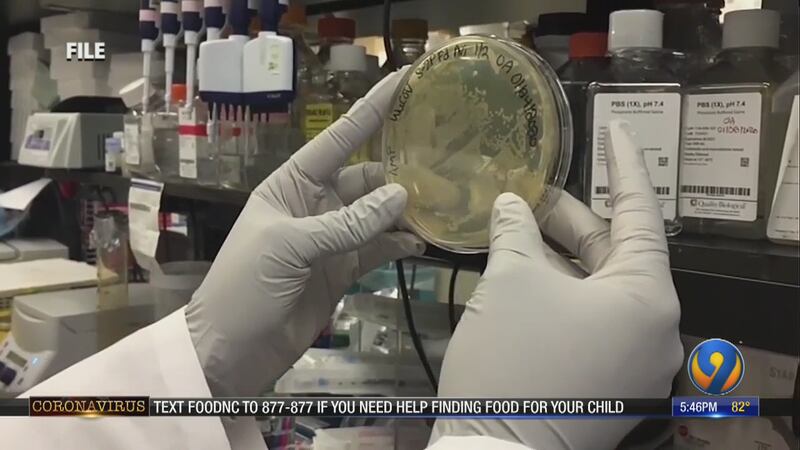

DURHAM, N.C. — (AP) — Duke University in North Carolina said campus housing this fall will be only for first- and second-year students as a way to prevent the spread of COVID-19.
Provost Sally Kornbluth wrote in an email to faculty that upperclassmen and graduate students will take online classes in the fall semester.
The News & Observer of Raleigh reports juniors and seniors will have access to libraries and labs but not residence or dining halls.
This represents a schedule modification for Duke, which is set to begin classes Aug. 17. Duke previously had upperclassmen arriving at school a couple of days before the semester’s start.
Cox Media Group